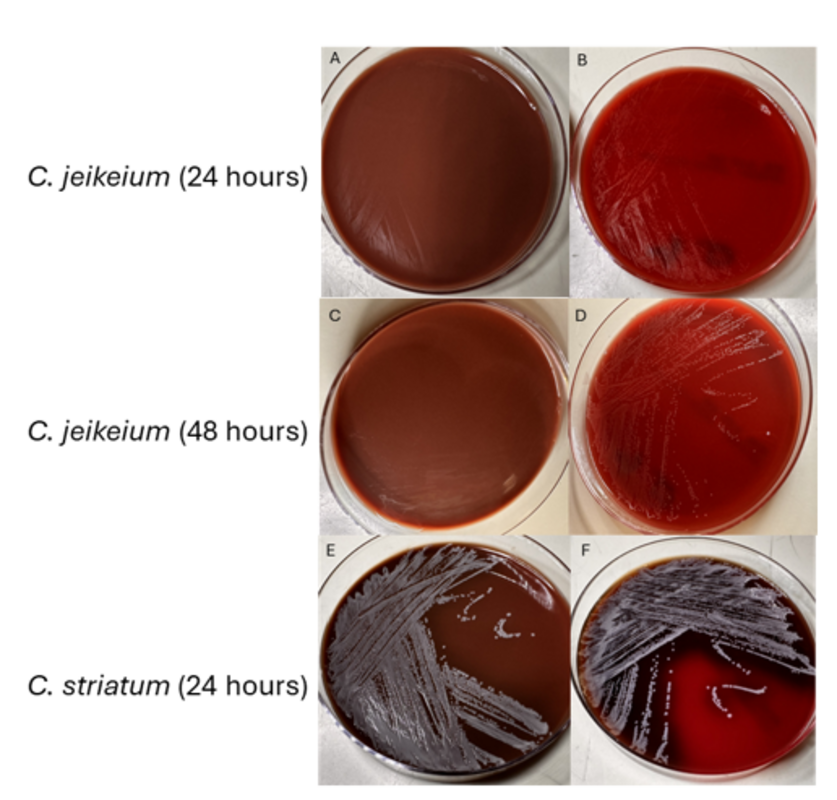

Женщина 70 лет с историей болезни, связанной с лечением острого миелоидного лейкоза с абсолютной нейтропенией вследствие химиотерапии, поступила в отделение неотложной помощи с двухдневной историей лихорадки с прогрессивно нарастающей эритемой и болезненностью в области правого локтя вокруг заживающего хирургического разреза.
Примерно за месяц до поступления пациентка перенесла хирургическое иссечение цефалической вены правой верхней конечности в связи с тромбофлебитом, возникшим как осложнение после введения периферической капельницы. Кроме того, за две недели до поступления пациентки на амбулаторный прием к хирургу было отмечено наличие трех небольших участков (< 1 см) расхождения раны вдоль хирургического разреза без явных признаков инфекции (илл. 1А). Эти участки были забинтованы йодоформной марлей и обернуты стерильной марлевой пленкой «Керликс», а затем эластичной пленкой. Пациентке было предписано менять повязку и наполнитель один-два раза в день; однако пациентка сообщила о несоблюдении этих инструкций, и повязка и наполнитель не менялись в течение двух недель с момента посещения клиники до поступления в отделение неотложной помощи.

Иллюстрация 1. Фотографии раны правой верхней конечности. Снимок A был получен за две недели до поступления на амбулаторный прием к хирургу, на нем видны три небольших участка расхождения раны (черные стрелки), но нет явных признаков инфекции. Изображение B было получено при поступлении и показывает три участка расхождения раны, заполненные старой йодоформной марлей, с эритемой вокруг хирургического разреза. На снимке C, сделанном через ~24 часа после снимка B, видно ухудшение и прогрессирование кожной эритемы вокруг раны.
Пациентка была госпитализирована. Были взяты образцы крови и начато внутривенное введение ванкомицина, цефепима и метронидазола для эмпирической антимикробной терапии в связи с нейтропенической лихорадкой и целлюлитом. Через 18 часов после забора в обоих наборах культур выросли грамположительные палочки. Впоследствии была проведена консультация со службой инфекционных заболеваний, чтобы провести идентификацию грамположительных палочек, выросших в культуре крови, и определить, являются ли они контаминантом или истинным патогеном.
Для дальнейшей оценки степени распространения инфекции кожи и мягких тканей была проведена компьютерная томография плеча и предплечья, которая выявила толстостенное скопление жидкости, свидетельствующее о формировании абсцесса в месте операции, охватывающее как плечо, так и предплечье пациентки (илл. 2). Также была проведена консультация со службой пластической хирургии, которая обратила внимание на старую йодоформную марлю в области расхождения раны с окружающей эритемой (илл. 1В); однако нагноения из этих областей не было.
В период госпитализации эритема вокруг раны продолжала прогрессировать (илл. 1С), а у пациентки сохранялась лихорадка, несмотря на прием антибиотиков широкого спектра действия. Учитывая безуспешность медикаментозного лечения, пациентка была направлена на хирургическую обработку раны. Во время операции были получены культуры глубоких тканей. Как в культуре тканей, так и в культуре крови была обнаружена Corynebacterium jeikeium. Через несколько дней после поступления у пациентки появилась макулопапулезная кожная сыпь, которая была расценена как сыпь, вызванная приемом антибиотиков. Схема антимикробной терапии была сужена до даптомицина из-за опасений, что ванкомицин и/или цефепим могут быть причиной медикаментозной сыпи. Целлюлит и абсцесс разрешились после хирургической обработки и лечения ванкомицином/даптомицином, однако пациентка решила продолжить лечение в комфортном режиме из-за злокачественной опухоли. Она была переведена в стационарный хоспис где вскоре умерла из-за прогрессирования лейкоза.

Иллюстрация 2. Компьютерная топография с контрастированием. На снимках плечевой кости (изображение A) и предплечья (изображение B) выявлено вероятное образование абсцесса (белые стрелки) длиной около 6,8 см и размером около 1,5 см в наибольшем измерении как на плечевой кости, так и на предплечье.
Виды Corynebacterium - это неподвижные, факультативно-анаэробные, булавовидные грамположительные палочки, имеющие характерный вид "изгороди из штакетника" при окрашивании, за счет отщепляющегося деления. Эти организмы часто встречаются в клинических образцах; однако, учитывая их низкую вирулентность в целом и распространенность в качестве обычной кожной флоры, их часто считают контаминантами или колонизаторами.
Клиническое значение штаммов, продуцирующих дифтерийный токсин (ДТ), известно уже несколько десятилетий. Виды Corynebacterium, не продуцирующие ДТ, исторически считались невирулентными, но в последние годы было отмечено, что некоторые виды Corynebacterium, не продуцирующие ДТ, являются патогенными. Широкое применение масс-спектрометрии MALDI-TOF в большинстве клинических микробиологических лабораторий позволило быстро и точно идентифицировать Corynebacterium на уровне видов, что дает возможность выявлять эти патогенные виды в клинических условиях.
Некоторые виды Corynebacterium обладают высокой липофильностью из-за наличия в их клеточной стенке жирных кислот, таких как миколовая кислота. Выделение липофильных видов Corynebacterium на стандартных культуральных средах может быть сложной задачей, но может быть осуществлено с использованием кровяного агара, благодаря наличию липидсодержащих мембран эритроцитов, при инкубации не менее 48 часов. Для оптимального выделения липофильных штаммов агар, дополненный Tween 80, дает наилучшие показатели выделения.
Как липофильный вид, C. jeikeium может быть трудно идентифицировать и культивировать. Он плохо растет на шоколадном агаре (илл. 3A и 3C). На кровяном агаре он имеет тенденцию к скудному или тусклому росту в течение 24 часов (илл. 3B) и появляется в виде полупрозрачных, точечных колоний в течение 48 часов (илл. 3D). Идентификация с помощью MALDI-TOF может быть затруднена до 48 часов из-за его плохого роста на стандартных средах. Для сравнения, C. striatum, нелипофильный вид Corynebacterium spp. относительно хорошо растет как на кровяном, так и на шоколадном агаре. Известно, что некоторые виды Corynebacterium, включая C. jeikeium и C. striatum, обладают множественной лекарственной резистентностью, особенно к бета-лактамным антибиотикам.
Иллюстрация 3. Изображения вторичных культур C. jeikeium и C. striatum, инокулированных на шоколадный агар (левая колонка) и кровяной агар (правая колонка) и инкубированных аэробно при 35°C в течение 24-48 часов.
Обсуждение
Corynebacterium jeikeium была первоначально идентифицирована в 1976 году и отнесена CDC к группе JK дифтероидов. Она считается частью нормальной кожной флоры, как и большинство других видов Corynebacterium spp. У лиц с иммуносупрессией, особенно у лиц с гематолимфоидными злокачественными опухолями, отмечались случаи инвазивных заболеваний, включая диссеминированные инфекции. Инфекции также могут наблюдаться при аппаратно-ассоциированных инфекциях и инфекциях, связанных с протезированием суставов. В этих случаях из-за склонности к образованию биопленок C. jeikeium может быть трудно поддаваться лечению. Сообщалось также о случаях инфекционного эндокардита.
Как и многие другие виды Corynebacterium, C. jeikeium часто обладает множественной лекарственной резистентностью. Ванкомицин является препаратом первой линии для лечения инфекций, вызванных C. jeikeium. Линезолид и даптомицин - другие альтернативные варианты лечения. При выделении C. jeikeium из крови, особенно у пациентов с ослабленным иммунитетом, как в нашем случае, врачи и другие медицинские работники должны тщательно оценить общую клиническую картину, прежде чем отвергать ее как контаминант.
